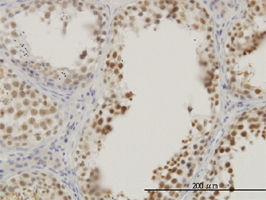

Filters
Clonality
Type
Reactivity
Gene Name
Isotype
Host
Application
Clone
2745 results for " Recombinant Antibodies" - showing 1250-1300
STK33, Monoclonal Antibody (Cat# AAA24674)
ACTB, Monoclonal Antibody (Cat# AAA24416)
RLIM, Monoclonal Antibody (Cat# AAA24931)
NMI, Monoclonal Antibody (Cat# AAA25179)
MKNK2, Monoclonal Antibody (Cat# AAA26460)
ACTN4, Monoclonal Antibody (Cat# AAA24417)
IFI16, Polyclonal Antibody (Cat# AAA28269)
CITED1, Monoclonal Antibody (Cat# AAA24170)
TGIF2, Monoclonal Antibody (Cat# AAA24682)
RRAS2, Monoclonal Antibody (Cat# AAA24938)
MKRN2, Monoclonal Antibody (Cat# AAA25458)
NADK, Monoclonal Antibody (Cat# AAA25464)
USF2, Monoclonal Antibody (Cat# AAA24698)
MCM3, Monoclonal Antibody (Cat# AAA25980)
P15RS, Monoclonal Antibody (Cat# AAA25481)
EFHD1, Monoclonal Antibody (Cat# AAA24196)
RAD51C, Monoclonal Antibody (Cat# AAA25223)
LETM1 and EF-hand Domain Containing Protein 1, Monoclonal Antibody (Cat# AAA25735)
KHDRBS1, Monoclonal Antibody (Cat# AAA25730)
FGR, Monoclonal Antibody (Cat# AAA24210)
TGIF2, Monoclonal Antibody (Cat# AAA24978)
LZTFL1, Monoclonal Antibody (Cat# AAA25739)
PCDH8, Monoclonal Antibody (Cat# AAA25485)
TCF19, Monoclonal Antibody (Cat# AAA24977)
FLJ23356, Monoclonal Antibody (Cat# AAA24214)
S100A6, Monoclonal Antibody (Cat# AAA25239)
ALB, Monoclonal Antibody (Cat# AAA24725)
CLK3, Monoclonal Antibody (Cat# AAA24467)
BATF, Monoclonal Antibody (Cat# AAA24737)
STIP1, Monoclonal Antibody (Cat# AAA26015)
Cyclophilin E, Monoclonal Antibody (Cat# AAA24478)
HDAC1, Monoclonal Antibody (Cat# AAA24235)
DYRK1A, Monoclonal Antibody (Cat# AAA24491)
HHIP, Monoclonal Antibody (Cat# AAA24236)
EFHD1, Monoclonal Antibody (Cat# AAA24492)
SOX9, Monoclonal Antibody (Cat# AAA25260)
CAMKIV, Monoclonal Antibody (Cat# AAA24743)
PRPF19, Monoclonal Antibody (Cat# AAA25510)
CCT7, Monoclonal Antibody (Cat# AAA24749)
STK33, Monoclonal Antibody (Cat# AAA25266)
CSE1L, Monoclonal Antibody (Cat# AAA26290)
ACP1, Monoclonal Antibody (Cat# AAA25006)
RASSF8, Monoclonal Antibody (Cat# AAA25518)
PCDH8, Monoclonal Antibody (Cat# AAA25781)
CPSF3, Monoclonal Antibody (Cat# AAA24765)
RRAS2, Monoclonal Antibody (Cat# AAA25528)
RRAS2, Monoclonal Antibody (Cat# AAA14777)
Purified by Protein A affinity chromatography.